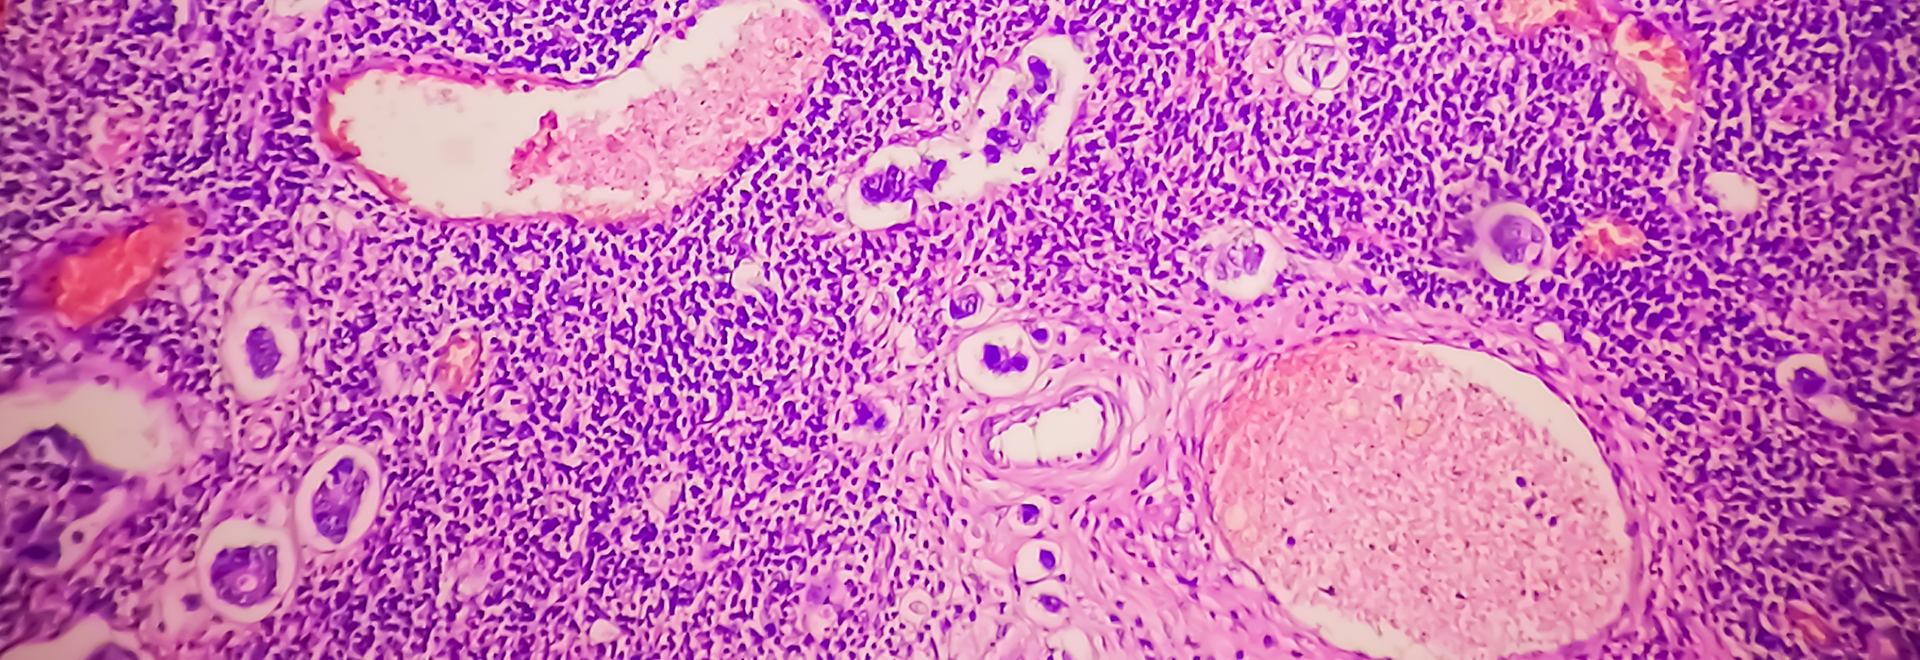

Dr Fedor Berditchevski
Reader in Epithelial Biology
Staff profile for Dr Fedor Beditchevski, Reader in Epithelial Biology, Department of Cancer and Genomic Sciences, College of Medicine and Health, University of Birmingham

Our main goal is to understand how normal cells change to become cancerous and how cancer cells grow and spread to form metastatic lesions.
The Breast Cancer Cell Biology Group examines molecular pathways which control responses of breast cancer cells to various extracellular stimuli. We are specifically focused on regulation signalling via cell adhesion proteins of integrin superfamily and receptor tyrosine kinases.
We found that activities of these receptors can be regulated by tetraspanins, a family of four transmembrane domain proteins. Tetraspanins facilitate assembly of dynamic molecular aggregates on the cell surface which we named as tetraspanin-enriched microdomains (or TERMs).
Expression levels of various tetraspanin proteins and composition of TERMs are changed during the metastatic progression in breast cancer. We found that clustering of transmembrane proteins within TERMs and tetraspanin-dependent recruitment of cytoplasmic proteins to these microdomains coordinates a diverse range of signalling pathways which control behaviour of breast cancer cells.
We use various breast cancer model systems by growing human breast cancer cells in three dimensional extracellular matrix (3-D ECM) in combination with other cell types to mimic the effect of tumour microenvironment. We developed specialised imaging and biochemical approaches to analyse the role of tetraspanins in signalling in breast cancer cells cultured in 3D ECM.
Advanced proteomic analysis provides information on changes in composition of TERMs associated with progression in breast cancer. Together with structural biology approaches these data are used to pinpoint specific signalling pathways which control assembly of tetraspanin complexes.
ErbB2/HER-2 is a member of the family of epidermal growth factor receptors. When overexpressed (e.g. in 15-25% of breast cancers), ErbB2 forms spontaneous homo- and heterodimers, which can drive tumour cell proliferation and metastasis. Although targeting ErbB2-dependent pathway with Herceptin/Trastuzumab (humanized anti-ErbB2 mAb) and Lapatinib (a small molecule tyrosine kinase inhibitor), has proven to be effective in ErbB2-overexpressing breast cancer patients, a significant proportion of them do not (or only partially) respond to the treatment.
We develop a model system in vitro to investigate how transmembrane proteins of the tetraspanin superfamily regulate responses of breast cancer cells to Herceptin and Lapatinib. Understanding molecular pathways which link the activity of tetraspanin complexes with ErbB2 will help to identify novel drug targets and develop a more effective protocol for the treatment of ErbB2-positive patients.
Bidirectional Eph-Ephrin signalling axis controls tissue differentiation and normal organ homeostasis. Abnormal activation of Eph – and Ephrin-dependent signalling is also a critical factor in tumourigenesis and metastasis. We investigate signalling mechanisms which regulate trafficking of activated EphrinB molecules in breast cancer cells and how this affects growth of cells inside three dimensional extracellular matrices.
Endocytic trafficking of transmembrane receptors controls intracellular signalling network and determines responses of breast cancer cells to extracellular environment. We study the composition and assembly of tetraspanin-based protein complexes which influence endocytic trafficking routes of transmembrane receptors.
Ruzisca Bago
Michael Parks
Izabela Bombik